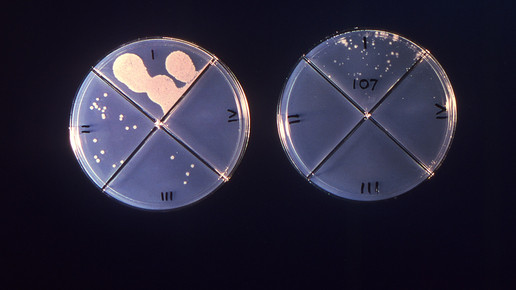
Tuberkuloseverdacht in Kita

Tuberkuloseverdacht in Kita
In einem Saalfelder Kindergarten ist ein Kind möglicherweise an Tuberkulose erkrankt. Das Gesundheitsamt des
Landkreises Saalfeld-Rudolstadt sei über den Verdachtsfall informiert worden, teilte das Landratsamt am Dienstag mit. Bislang seien bei dem Kind jedoch keine Symptome aufgetreten, die auf eine Erkrankung schließen ließen.
In der Familie des Kindes sei die Krankheit schon einmal vorgekommen, hieß es weiter. Seither stand es als enge Kontaktperson unter regelmäßiger Überwachung und wurde vorbeugend mit einem Medikament behandelt. Im Oktober sei dann ein Kontrolltest positiv ausgefallen. Deshalb wurde das Kind nochmals untersucht, wobei erste Befunde zu der Verdachtsmeldung geführt hätten.
Zum eindeutigen Nachweis einer ansteckungsfähigen Tuberkulose fehlt der Mitteilung zufolge aber bisher der Nachweis des Erregers. Dennoch habe das Gesundheitsamt entschieden, vorsorglich einen freiwilligen Test für alle Kinder der Einrichtung anzubieten. Die Eltern seien über den Fall informiert worden und könnten sich während des gesamten Prozesses an die Mitarbeiter des Gesundheitsamtes wenden.

APOTHEKE ADHOC Debatte